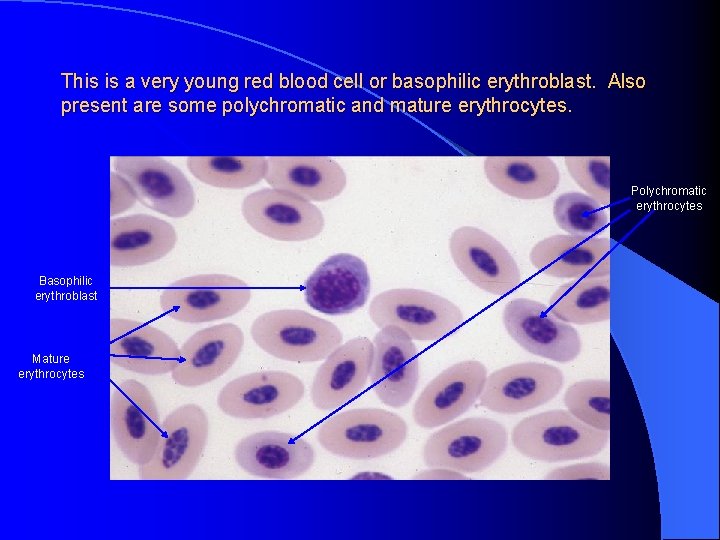
This is a very young red blood cell or basophilic erythroblast. Also present are
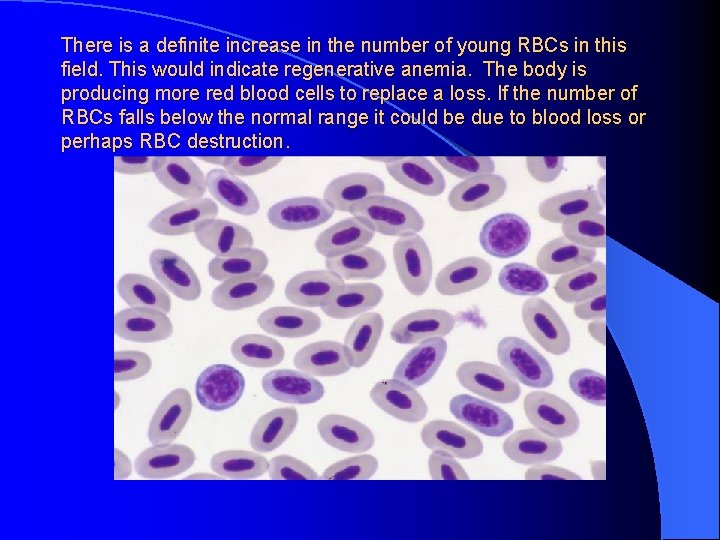
There is a definite increase in the number of young RBCs in this field.
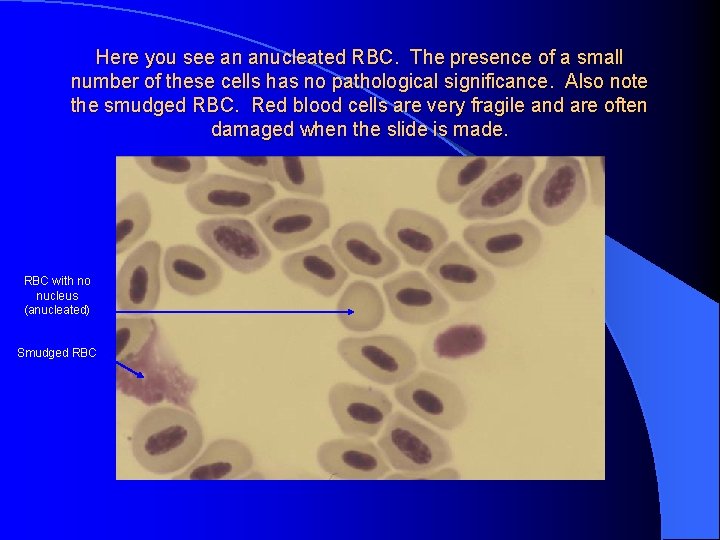
Here you see an anucleated RBC. The presence of a small number of these
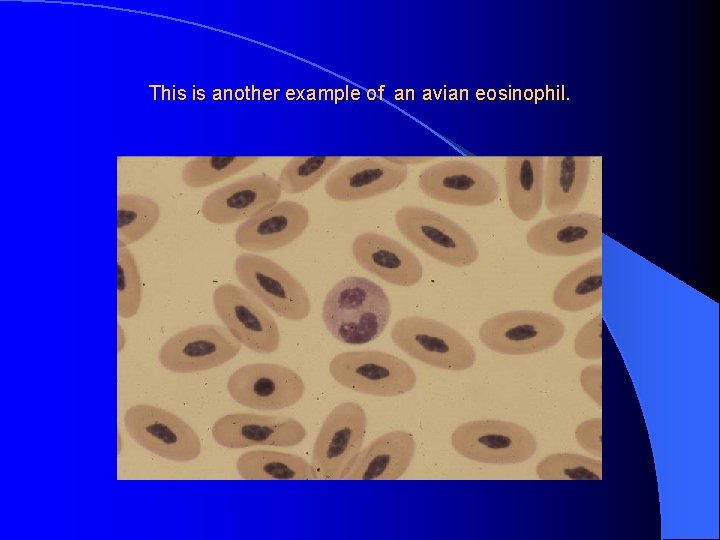
This is another example of an avian eosinophil.
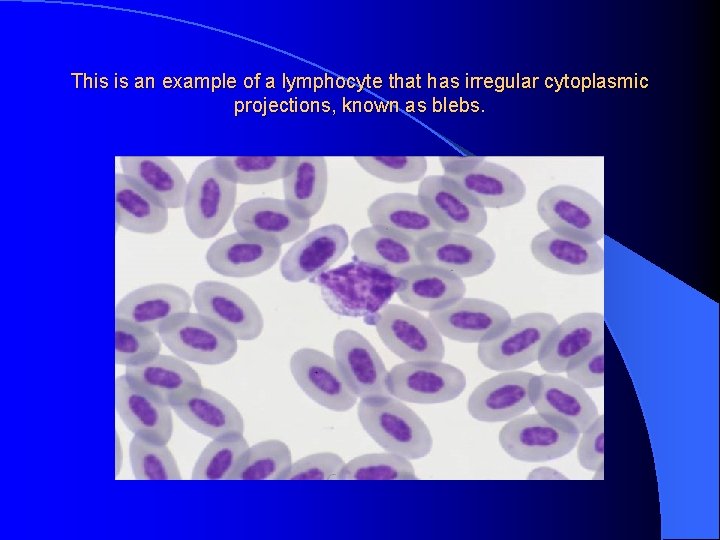
This is an example of a lymphocyte that has irregular cytoplasmic projections, known as
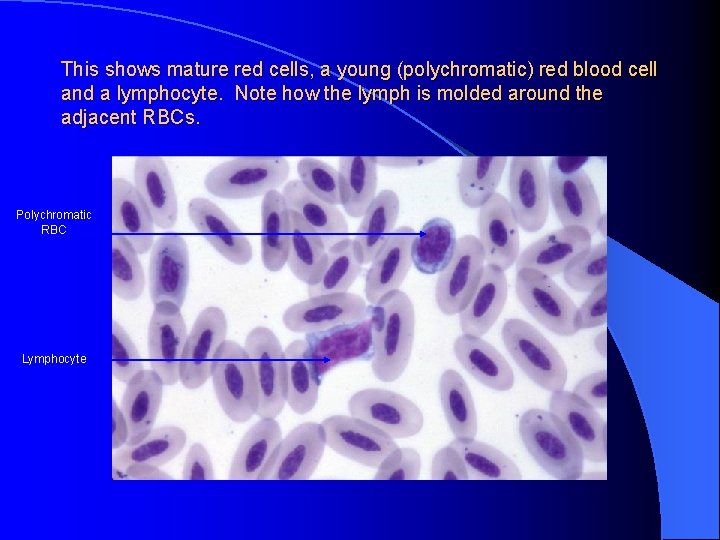
This shows mature red cells, a young (polychromatic) red blood cell and a lymphocyte.
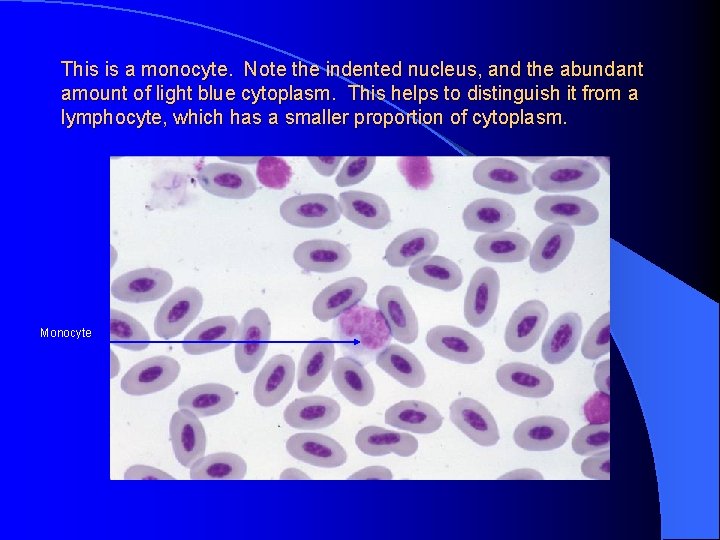
This is a monocyte. Note the indented nucleus, and the abundant amount of light
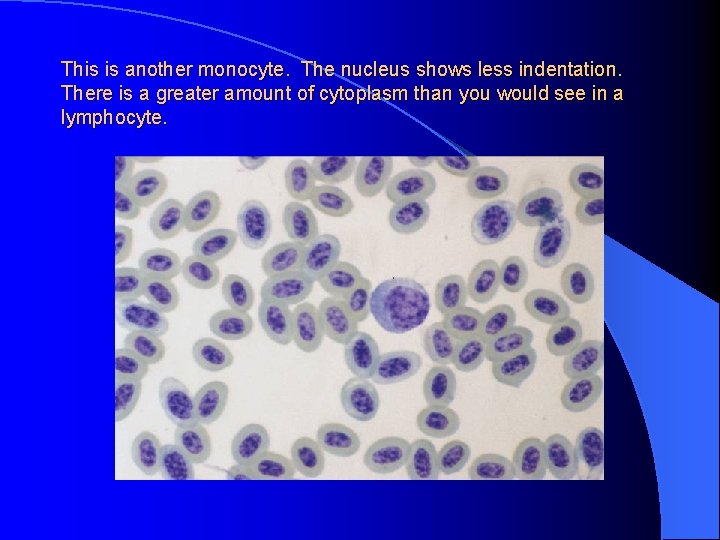
This is another monocyte. The nucleus shows less indentation. There is a greater amount
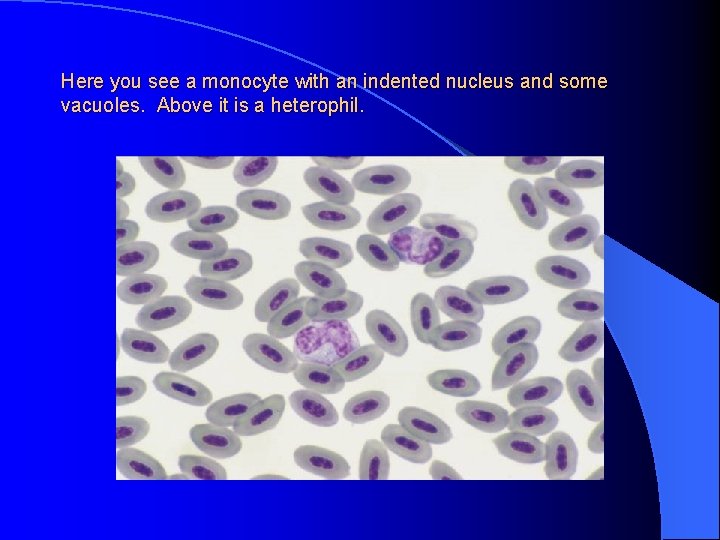
Here you see a monocyte with an indented nucleus and some vacuoles. Above it

Avian Hematology Slides Avian RBC maturationThe younger cells

Avian Hematology Slides

Avian RBC maturation-The younger cells are smaller, rounder and have a more basophilic cytoplasm. Mature erythrocytes are oval with eosinophilic cytoplasm. The nuclear size decreases and the amount of cytoplasm increases as the cell matures. Polychromatic (younger) RBCs Basophilic (even younger) erythroblast Mature erythrocytes
This is a very young red blood cell or basophilic erythroblast. Also present are some polychromatic and mature erythrocytes. Polychromatic erythrocytes Basophilic erythroblast Mature erythrocytes
There is a definite increase in the number of young RBCs in this field. This would indicate regenerative anemia. The body is producing more red blood cells to replace a loss. If the number of RBCs falls below the normal range it could be due to blood loss or perhaps RBC destruction.
Here you see an anucleated RBC. The presence of a small number of these cells has no pathological significance. Also note the smudged RBC. Red blood cells are very fragile and are often damaged when the slide is made. RBC with no nucleus (anucleated) Smudged RBC

These are typical avian white blood cells. The heterophil (on the right) is round with round red granules in the clear cytoplasm. The eosinophil is also round with a blue-gray cytoplasm and stains more noticeably than the heterophil. Eosinophil Heterophil
This is another example of an avian eosinophil.

This is an example of a heterophil that is broken, revealing rodshaped, red granules.

This is an example of a basophil. The cell is round and contains a nucleus that is light blue in color. It has a large number of deeply basophilic-staining granules that almost cover the nucleus.

This field contains a heterophil (at top) and a lymphocyte. The heterophil has rod-shaped granules. The lymphocyte is molded around the adjacent cells. There is a high nuclear to cytoplasmic ratio in the lymphocyte.
This is an example of a lymphocyte that has irregular cytoplasmic projections, known as blebs.

Another lymph with blebs
This shows mature red cells, a young (polychromatic) red blood cell and a lymphocyte. Note how the lymph is molded around the adjacent RBCs. Polychromatic RBC Lymphocyte

This blood is from a white-winged dove. Their lymphocytes have granules in the cytoplasm. Lymphocyte

This is a small lymphocyte showing very little cytoplasm.
This is a monocyte. Note the indented nucleus, and the abundant amount of light blue cytoplasm. This helps to distinguish it from a lymphocyte, which has a smaller proportion of cytoplasm. Monocyte
This is another monocyte. The nucleus shows less indentation. There is a greater amount of cytoplasm than you would see in a lymphocyte.
Here you see a monocyte with an indented nucleus and some vacuoles. Above it is a heterophil.

These are clumped thrombocytes. Note that they are small, usually more rounded than RBCs, hand have clear cytoplasm.

Here is another thrombocyte.

Here we see a heterophil (left), a lymphocyte (center) and a monocyte (right).

All of the hematology slides in this presentation were generously donated by Dr. David Phalen, Associate Professor of Large Animal Medicine and Surgery, Texas A&M University.
- Slides: 22